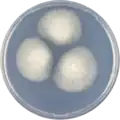
Aspergillus cejpii growing on CYA plate

Aspergillus cejpii
| Aspergillus cejpii | |
|---|---|
| Scientific classification | |
| Kingdom: | Fungi |
| Division: | Ascomycota |
| Class: | Eurotiomycetes |
| Order: | Eurotiales |
| Family: | Aspergillaceae |
| Genus: | Aspergillus |
| Species: | A. cejpii
|
| Binomial name | |
| Aspergillus cejpii (Milko) Samson, Varga, Visagie & Houbraken 2014[1]
| |
| Type strain | |
| CBS 157.66 | |
| Synonyms | |
Aspergillus cejpii is a species of fungus in the genus Aspergillus.[1][2][3] It is from the Clavati section.[4] The species was first described in 1975.[5] Aspergillus cejpii produces gliotoxin, acetylgliotoxin G, fiscalin B and xanthocillin X.[6]
Growth and morphology
A. cejpii has been cultivated on both Czapek yeast extract agar (CYA) plates and Malt Extract Agar Oxoid® (MEAOX) plates. The growth morphology of the colonies can be seen in the pictures below.
-
Aspergillus cejpii growing on CYA plate
Aspergillus cejpii growing on CYA plate -
 Aspergillus cejpii growing on MEAOX plate
Aspergillus cejpii growing on MEAOX plate
References
- ^ a b Samson R.A.; Visagie, C.M.; Houbraken, J.; Hong, S-B.; Hubka, V.; Klaassen C.H.W.; Perrone, G.; Seifert, K.; Susca, A.; Tanney, J.B.; Varga, J.; Kocsube, S.; Szigeti, G.; Yaguchi, T.; Frisvad, J.C. 2014. Phylogeny, identification and nomenclature of the genus Aspergillus. Studies in Mycology. 78:141-173
- ^ a b c "Aspergillus cejpii". www.uniprot.org.
- ^ "A. cejpii | Aspergillus & Aspergillosis Website". www.aspergillus.org.uk.
- ^ Varga, J.; Due, M.; Frisvad, J.C.; Samson, R.A. (2007). "Taxonomic revision of Aspergillus section Clavati based on molecular, morphological and physiological data". Studies in Mycology. 59: 89–106. doi:10.3114/sim.2007.59.11. PMC 2275193. PMID 18490946.
- ^ Rai, J.N.; Wadhwani, K.; Agarwal, S.C. 1975. Aspergillus rhizopodus sp.nov. from Indian alkaline soils. Transactions of the British Mycological Society. 64(3):515-517
- ^ Lamoth, Frederic; Steinbach, William J. (2016). Advances in Aspergillus fumigatus pathobiology. Frontiers Media SA. ISBN 9782889197897.
Further reading
- Kocsubé, S.; Perrone, G.; Magistà, D.; Houbraken, J.; Varga, J.; Szigeti, G.; Hubka, V.; Hong, S.-B.; Frisvad, J.C.; Samson, R.A. (September 2016). "Aspergillus is monophyletic: Evidence from multiple gene phylogenies and extrolites profiles". Studies in Mycology. 85: 199–213. doi:10.1016/j.simyco.2016.11.006. PMC 5220211. PMID 28082760.